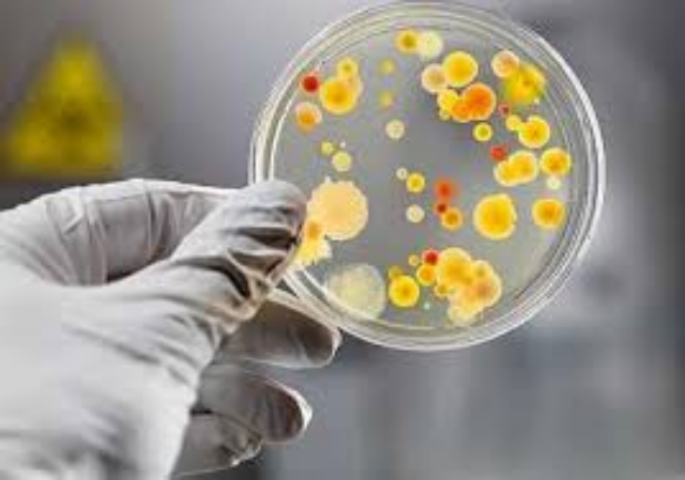
Ботулизм в Украине: проблемы безопасности продуктов питания

Ботулизм в Украине: проблемы безопасности продуктов питания
Ранее Domik.ua сообщал о том, что в Украину три года не ввозят сыворотки от яда и ботулизма.
В конце мая в Киеве от ботулизма умер мужчина, купивший вяленую рыбу в супермаркете. От продукции того же производителя из Кировоградской области пострадало еще несколько человек из других регионов. Врачи предупреждают: сыворотки от этой болезни в больничных стационарах нет. В Минздраве надеются на гуманитарную помощь от зарубежных организаций. В то же время, эксперты по защите прав потребителей говорят, что за последние три года в Украине возросло количество вредных и опасных для здоровья продуктов питания. Мы разобрались, почему их качество снизилось, и как лечат заболевших опасными заболеваниями.
Несвежие покупки
С конца мая в стране было зарегистрировано девять случаев заболевания ботулизмом. Четыре из них - в столице, один - в Киевской области, два - в Винницкой, и еще по одному в Херсонской и Сумской. Все пострадавшие употребляли вяленую рыбу, изготовленную на украинских предприятиях, сообщили в Государственной службе по вопросам безопасности продуктов питания и защиты прав потребителей. В целом, с начала года сотрудники ведомства участвовали в расследовании 21 случая заболевания ботулизмом, связанного с употреблением рыбной продукции. Три из них – с летальным исходом . В основном, это была копченая или вяленая рыба, изготовленная в домашних условиях или купленная на стихийных рынках.
По словам главного инфекциониста МОЗ Украины, заведующей кафедрой инфекционных болезней НМУ имени А.А. Богомольца, профессора Ольги Голубовской, в прошлом году в Украине было зафиксировано около 100 случаев ботулизма. Тогда умерло девять человек. За последние полтора месяца в Александровскую клиническую больницу города Киева с этим диагнозом попало шесть человек. Как сообщила Голубовская, все они отравились вяленой рыбой из супермаркетов. Один пациент умер, еще один - на лечении, а остальных уже выписали.
Читайте также: Чем может обернуться для украинцев запрет на ввоз лекарств из России
Результаты эпидемиологического расследования, которое проводило Главное управление Государственной службы по вопросам безопасности продуктов питания и защиты прав потребителей (далее - Госпродпотребслужба) в городе Киеве показали, что все случаи ботулизма за последние две недели связаны с продукцией промышленного производства. Производитель - ФОП Меркулов А.В., а поставщик - ООО "ЧУДО-ЮДО". Обе фирмы находятся в городе Светловодск Кировоградской области. Все пострадавшие покупали рыбу в "Мегамаркете", "Караване" и "Ашане". Как отметил начальник главного управления Госпродпотребслужбы в городе Киеве Олег Рубан, отравление вяленой рыбой в Херсоне также связано с тем же производителем из Светловодска.
Рубан подчеркнул, что крупные супермаркеты за отравления покупателей ответственность не несет, поскольку они получили продукцию вместе со всеми необходимыми разрешительными документами. "Это исключительно вина производителя, потому что "Ашан" и другие сети, которые продают этот продукт, берут его с гарантиями качества и сопроводительными документами. Им были предоставлены все документы", - сообщил он.
Впрочем, проблема заключается в том, что украинские супермаркеты во время приема продукции не ведут выборочный контроль, рассказал зампредседателя правления Союза потребителей Украины Олег Цильвик. Торговые сети не проверяют, соответствует ли реальное качество продуктов тому, что указано в документах.
Глава киевского управления Госпродпотребслужбы отметил, что с 29 мая в Киеве запрещена торговля рыбой производителя из Светловодска. Полторы тонны продукта было изъято в магазинах столицы, и сейчас проводится ее анализ. "Но потом она каким-то фантастическим образом попала на стихийный рынок, где тоже национальная полиция запретила ее реализацию", - рассказал Олег Рубан. Указание про снятие с реализации рыбы данной торговой марки также было направлено во все регионы Украины. Но на сегодня этот вопрос находится исключительно в зоне ответственности территориальных органов Госпродпотребслужбы в каждом регионе, подчеркнул Рубан.
По его словам, на сегодня Служба ежедневно следит за тем, чтобы ни один магазин Киева не продавал вяленую рыбу ФОП Меркулов. Кроме того, ведется контроль, чтобы продукт не завозили в столицу. Само предприятие также приостановило производство до окончания расследования. Рубан резюмировал, что за последние десять лет это первый случай заражения ботулизмом из-за продукции промышленного производства.
Читайте также: Как получить бесплатные лекарства
Опасные симптомы
Врач-инфекционист Ольга Голубовская рассказала изданию, что симптоматика ботулизма отличается от обычного отравления. У пациентов, зачастую, отсутствует рвота и температура. При этом, инкубационный период длится от нескольких часов до десяти дней. Чем он длиннее, тем благоприятнее течение заболевания. У человека, в организм которого попал ботулотоксин, нарушается зрение, появляется слабость (астения), нарушается процесс глотания, который становиться весьма болезненным. Врачи говорят о том, что ботулизм требует немедленной госпитализации и не рекомендуют заниматься промыванием желудка в домашних условиях. Одной из особенностей лечения ботулизма является то, что помочь пациенту может лишь специальная противоботулическая сыворотка. Она представляет собой антидот, содержащий иммуноглобулины. Чем раньше она введена пациенту, заразившемуся ботулизмом, тем больше его шансы на скорейшее выздоровление.
Голубовская отметила, что врачи прогнозировали рост заболеваемости ботулизмом еще два года назад. По ее словам, аналогичная вспышка этого заболевания была в 90-х годах, ведь ботулизм развивается во времена кризиса, когда население переходит на более дешевые продукты. Но 20 лет назад в Украине не было проблем с противоботулической сывороткой. Кроме того, люди получали отравления в основном из-за домашней консервации: грибов, паштетов, колбасы. Массовых случаев отравления продуктами, купленными в магазинах, не было. "Для любой страны отравление продуктами, купленными в супермаркетах - это просто ЧП", - возмутилась врач.
Ольга Голубовская уточнила, что в украинских стационарах сыворотки от ботулизма нет с 2014 года. Противоботулинические сыворотки не зарегистрированы сейчас в Украине. Есть разрешение Министерства здравоохранения на ввоз незарегистрированных препаратов, но нет разрешения на их медицинское использование. Поэтому врачи не знают, как им лечить пациентов. "Возникает юридическая коллизия, можно ли вообще врачам использовать эту сыворотку. Я консультировалась с юристами, и они сказали, что нельзя. Мне звонят врачи из Полтавы, из Сум, где тоже в последние дни есть случаи ботулизма и спрашивают, что им делать", - рассказывает Голубовская.
Родственникам пациентов приходится покупать контрабандную сыворотку за свой счет, а врачи могут использовать ее только на свой страх и риск. В интернете стоимость сыворотки разных типов (А и В) варьируется от 600 до 2600 гривен за упаковку (5 ампул по одной дозе каждая). Но прозвонив по нескольким указанным телефонам обнаруживается, что препарата в Украине либо нет, либо "нужно ждать до трех дней поставок из Европы". А, как известно, для пациента с явными симптомами ботулизма критичны первые 3-5 часов, в которые ему необходимо получить лекарство. Но если раньше при ботулизме врачи вводили сыворотку в течение получаса после поступления пациента в стационар, то теперь еще проходится ждать минимум несколько часов, а зачастую и полдня, пока родственники больного пытаются где-то достать антидот.
"Получается, что никто из больных ботулизмом в Украине не может рассчитывать на адекватную помощь. Врачи имеют полное право отказаться от использования сыворотки, так как она не зарегистрирована", - подчеркнула Голубовская. По словам врача, также непонятно, как закупать сыворотку на уровне регионов. "Незарегистрированные препараты регионам купить очень сложно, если не сказать невозможно. Это бюджетные деньги, первое, что спросят - какая есть потребность и как ее обосновать? На какое количество больных? У какого производителя?", - жалуется инфекционист. При этом она подчеркнула, что противоботулическая сыворотка европейского производства примерно в десять раз дороже российских аналогов. Тех, кто возьмет на себя смелость купить ее, могут обвинить в нерациональном использовании бюджетных средств. На сегодня Минздрав обосновал потребность в сыворотках с соответствующими расчётами. Теперь дело за Кабмином, который должен решить вопрос с выделением средств на закупку препаратов.
И.о. министра здравоохранения Уляна Супрун подтвердила, что проблема с нехваткой сывороток от ботулизма длится уже не первый год после истечения срока действия сертификата о государственной регистрации противоботулической сыворотки. Минздрав неоднократно обращался к производителям с просьбой о возможной государственной регистрации препаратов на территории Украины. "Они очень дешевые, и никто их не хочет регистрировать в Украине, потому что их нечасто используют. На самом деле, это не тысячи раз, это десятки", - отметила Супрун. Министерство уже обратилось в международную организацию ПРООН, чтобы та поставила в Украину сыворотку на условиях гуманитарной помощи.
Супрун уточнила, что врачи имеют право лечить людей сывороткой от ботулизма, которая поступила в виде гуманитарной помощи, если ее ввезли в страну легально. И то, что она не зарегистрирована в Украине, в данном случае не имеет значения. Минздрав также направил письмо в правительство с просьбой выделить дополнительные средства на закупку данных препаратов при внесении изменений в закон Украины о государственном бюджете на 2017 год.
Читайте также: Что будет с ценами после повышения пенсий: прогнозы экспертов
Фальсификат и кишечная палочка
Вспышка ботулизма и отсутствие сыворотки далеко не единственные проблемы в здравоохранении. С начала года территориальные органы Госпродпотребслужбы провели расследование 60 вспышек кишечных инфекционных заболеваний, в результате которых пострадало 747 человек. Большинство из них - дети. Впрочем, с продукцией из ресторанов и магазинов было связано лишь пять случаев обострения болезней. Основными причинами заболеваний были грубые нарушения санитарного законодательства, а именно - не соблюдение технологии приготовления блюд, условий хранения сырья и готовой продукции. Кроме того, в заведениях общепита нарушался режим дезинфекции, условия мытья кухонной и столовой посуды, а также правил личной гигиены персонала. В целом, по количеству заболеваний лидировали Одесская и Киевская области.
Среди этих причин зампредседателя правления Союза потребителей Украины Олег Цильвик на первое место поставил нарушение санитарных норм. По данным его организации, которая осуществляет постоянный мониторинг торговых сетей, ресторанов и кафе, оказывается, что у большинства персонала нет санитарных книжек, либо они фиктивные. То есть, нет гарантии, что они здоровы. Если у сотрудника есть в организме патогенная флора, то от него через продукцию может заразиться и покупатель.
Вторая проблема - использование некачественной продукции. "Например, в Киеве у супермаркетов выкупают продукты, у которых срок годности подходит к концу. Потом на них меняют маркировку и продают на стихийных рынках. Эти товары приобретают закусочные и шашлычные, которые стремятся купить продукты подешевле", - отмечает Цильвик.
Как рассказал руководитель центра экспертиз "ТЕСТ" Валентин Безрукий, в испорченных продуктах чаще всего попадаются бактерии группы "кишечная палочка". Кишечная палочка может быть условно патогенной, и патогенной. Второй вид встречается редко, но может привести к летальному исходу.
Кроме того, в продуктах периодически встречается сальмонелла. Вредные микроорганизмы попадают, в основном, в скоропортящуюся мясную и молочную продукцию. По словам Безрукого, больше всего рискуют те потребители, которые покупают еду на рынках, ведь в магазинах лучше следят за условиями хранения. Летом условия хранения соблюсти тяжелее, отмечает эксперт. "Если вы видите в магазине слипшиеся замороженные продукты, это значит, что они хранятся неправильно. То есть, они в какой-то момент оттаяли, а потом опять были заморожены", - подчеркивает Безрукий. По его словам, ботулические бактерии развиваются, в основном, в закрытых емкостях. Особенно - в консервах. Испорченный продукт можно определить по вздутой банке. Цильвик предостерегает от покупок рыбной продукции на рынках. Он отмечает, что современные технологии позволяют, например, использовать химические вещества, которые имитируют, как будто рыбу вялили на костре. "В интернете есть много объявлений по продаже оборудования для вяления, но кто вялит и в каких условиях остается только догадываться", - сетует эксперт.
Читайте также: На смену среднему классу в Украине пришел омникальный
По словам Цильвика, уровень безопасности и качества пищевых продуктов резко снизился с 2014 года после введения моратория на проверку бизнеса. Ситуацию усугубило преобразование Госпотребинспекции. По мнению Цильвика, то, что службу по вопросам безопасности продуктов питания и защиты прав потребителей создали на базе ветеринарной и фитосанитарной служб - неправильно. Он отмечает, что сейчас у службы не хватает кадров для надлежащего контроля над качеством продукции.
И даже закон о безопасности пищевой продукции, который был принят в прошлом году, не позволяет решить проблему. Документ предполагает, что все предприятия, которые имеют дело с едой, обязаны зарегистрироваться как субъекты предпринимательства, которые имеют отношение к пищевой продукции. Впоследствии они должны соблюдать соответствующие гигиенические нормы. Речь идет о всех компаниях, которые производят, транспортируют или продают продукты питания. Несмотря на то, что регистрация бесплатная, и за ее отсутствие полагается около 100 тыс. гривен штрафа, даже в Киеве зарегистрировалось чуть более половины предприятий. Это связано с отсутствием контроля, отмечает эксперт.
Значительное снижение качества пищи в последние три года связано, прежде всего, с желанием производителей удешевить продукцию любыми способами. Ведь покупательная способность снизилась во время кризиса. Самый распространенный путь - упрощение состава продукции. "Вместо качественной свинины или говядины торговые марки используют сырье, которое в замороженных блоках привезли несколько лет назад из Аргентины, например. Там почему-то мясо дешевле. Или производители используют более дешевые части животного", - жалуется Безрукий. По его словам, хорошо, когда на упаковке честно пишут состав. Но некоторые производители понижают качество своей продукции, впрочем, на этикетке указывается состав качеством выше.

Читайте также: Как изменится жизнь украинцев в ближайшие годы
Принципиальное отличие европейской системы контроля от украинской в том, что в ЕС четко прописаны критерии проверок пищевой продукции, рассказал генеральный директор Украинского клуба аграрного бизнеса Тарас Высоцкий. В то же время, в Украине есть контролирующий орган - Госпродпотребслужба, но в законе не прописаны эти критерии.
"В Украине действует мораторий на проведение проверок. А в Европе периодичность проверок зависит от категории товаров. То есть, она зависит от срока годности продуктов, от рисков, которые несет в себе деятельность предприятий", - подчеркнул эксперт. Он добавил, что в Европе отравления едой из супермаркетов - из ряда редких исключений. Высоцкий напомнил, что согласно Соглашению об ассоциации с ЕС, Украина обязалась проводить соответствующий европейскому государственный контроль за качеством пищевой продукции. С этой целью еще в 2014 году был написан законопроект "О государственном контроле, который осуществляется с целью проверки соответствия законодательству о безопасности и качестве пищевых продуктов и кормов, здоровья и благополучия животных" (№ 0906). Но в парламенте приняли документ только в середине мая. Сейчас документ на подписи у президента.



